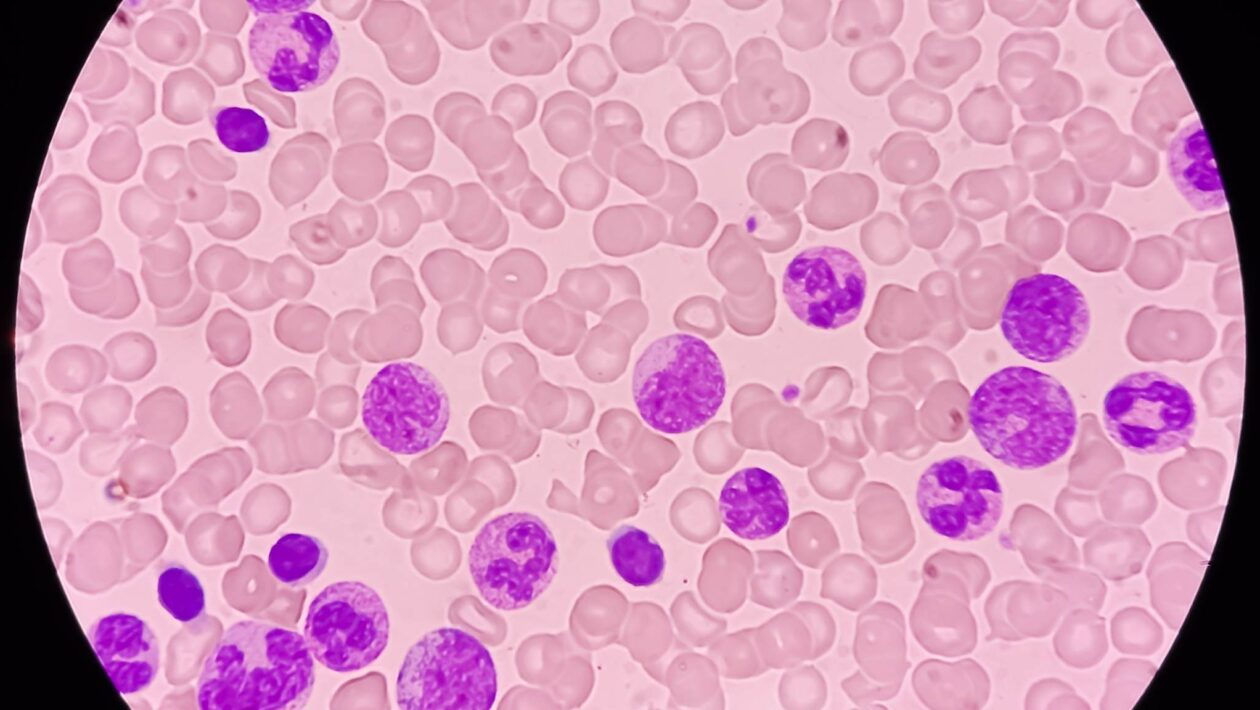
IA detecta células sanguíneas perigosas com precisão inédita (Imagem: Getty Images/ Canva Pro)

Um avanço promissor em inteligência artificial está mudando a forma como doenças sanguíneas são detectadas. Pesquisadores da Universidade de Cambridge, junto com o University College London e a Queen Mary University of London, desenvolveram o CytoDiffusion, um sistema de IA generativa capaz de analisar células sanguíneas com mais precisão que especialistas humanos, identificando alterações sutis que podem indicar doenças como a leucemia. O estudo foi publicado na Nature Machine Intelligence em 19 de novembro de 2025 (DOI: 10.1038/s42256-025-01122-7) por Simon Deltadahl et al..
Esta ferramenta não se limita a reconhecer padrões óbvios; ela examina variações mínimas na forma e estrutura das células, permitindo:
- Identificar células raras ou incomuns que podem sinalizar doenças;
- Quantificar a confiança em suas próprias análises, minimizando erros;
- Automatizar a triagem de milhares de células por esfregaço sanguíneo.
Como a IA supera os humanos na análise celular?
O diagnóstico de doenças hematológicas exige atenção extrema a pequenas diferenças entre células sanguíneas. Mesmo médicos experientes podem discordar em casos complexos, e a análise manual é limitada pelo tempo e volume de células. O CytoDiffusion processa cada esfregaço de forma rápida, destacando anomalias prioritárias para revisão humana, aumentando a eficiência clínica sem substituir os médicos.

O sistema foi treinado com mais de 500 mil imagens de esfregaços sanguíneos do Hospital Addenbrooke’s, criando um modelo robusto capaz de:
- Reconhecer toda a gama de aparências normais das células sanguíneas;
- Detectar células anormais associadas à leucemia com alta sensibilidade;
- Gerar imagens sintéticas realistas para validar e treinar novos modelos.
Implicações para a medicina e pesquisa global
Ao disponibilizar o maior conjunto público de imagens de células sanguíneas, a equipe promove democratização de dados médicos e incentiva novas pesquisas em IA médica. Além disso, o CytoDiffusion oferece uma “consciência metacognitiva”, reconhecendo suas próprias incertezas, algo crítico para decisões clínicas complexas. Embora ainda sejam necessários estudos para aumentar a velocidade e testar populações diversas, o potencial é enorme: diagnósticos mais rápidos, precisos e confiáveis, com o suporte da IA generativa transformando a hematologia moderna.